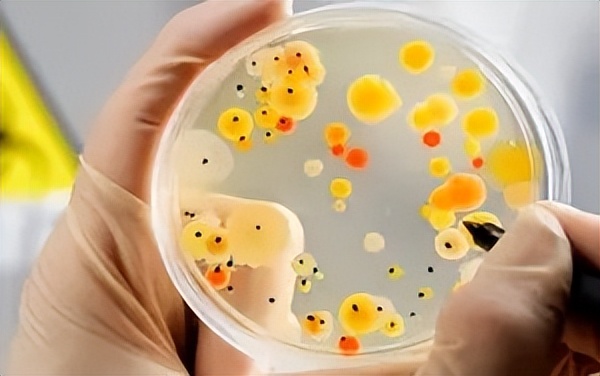
到了更年期得尿路感染怎么办,夏季女性尿路感染的主要原因

夏天来了,尿路感染进入高发季。有些人会突发小便很急,一点儿都憋不住,小便时又特别痛,想尿又不敢尿,甚至还有血尿、腰痛、小肚子坠痛等情况。尤其是糖尿病患者在这个季节更需要格外注意,他们比常人更易患尿路感染。

为何易患尿路感染,“糖”是“元凶”
众所周知,糖尿病会导致人体的抵抗力下降,从而引起机体出现各种感染。常见的感染有肺部感染、尿路感染和皮肤感染。尿路感染的发生率仅次于肺部感染,在临床中却往往被糖尿病患者所忽视。那为何糖尿病人容易尿路感染?
1. 血糖高:糖尿病患者由于尿液中葡萄糖含量高,给细菌生长繁殖提供了可乘之机。
2. 免疫力低下:糖尿病患者机体的免疫力比正常人低,抵抗细菌的能力不足,不能有效地杀灭细菌,更易发生尿路感染。
3. 特殊的生理结构:尤其是患有糖尿病的女性患者,因为女性的尿道短而宽,比男性更容易发生尿路感染。
4. 季节因素:天气炎热,出汗多,喝水量相对减少,达不到冲洗膀胱的目的,这样的环境有利于细菌的繁殖。
5. 年龄因素:对于处于更年期或已绝经的糖尿病女性患者,由于体内性激素水平下降,导致全身内环境的紊乱,更容易导致尿路感染,时常迁延不愈,而长期慢性尿路感染可以导致慢性肾脏病的发生。
此外,持续的高血糖状态还会损伤神经,造成神经源性膀胱,引发排尿异常、尿潴留。所以,在炎热的夏季,糖尿病患者尤其要注意预防尿路感染。
炎炎夏日,糖尿病人如何做到防患于未然?
1. 控好血糖
糖尿病患者要坚持按时服用降糖药或遵医嘱注射胰岛素,定期监测血糖,将血糖控制在接近正常水平。尿糖转为阴性或微量,可使尿路变为不利于细菌生长的环境,杜绝感染。
2. 规范治疗尿路感染
在治疗上,主要有西药抗生素和中成药,但抗生素有诸多副作用,对肝肾亦有损伤,且糖尿病患者多伴有肾功能低下,因此很多医生和患者会选择服用中成药治疗。
尿路感染在中医学中称为“淋证”,基本病机为湿热蓄膀胱之腑,湿热蕴注下焦。因为湿热壅遏,气机失宜,故排尿艰涩,灼热刺痛;湿热蕴蒸,故小便黄赤,溺频而急。

中医在治疗上,常以“清热除湿,利尿通淋”为主要原则。临床上有专治此症的中成药如复方石韦片,可起清热燥湿、利尿通淋之效。既可充分发挥中医药抗菌消炎的作用,又可增强机体的免疫力,避免疾病的反复发作。
3. 补充水分
夏天气候炎热,出汗多,很容易导致脱水,血液浓缩而变得黏稠,尿量少,易引发尿路感染。
因此,糖尿病患者要补足水分,即使不感口渴也要喝水,如白开水、淡茶水、绿豆汤等,喝水多,尿量增加,有利于冲刷尿道,防范尿路感染的发生。
4. 不要憋尿
糖尿病患者如果经常憋尿,当膀胱内尿液过多时,会对膀胱内膜造成伤害,降低膀胱黏膜的抵抗力,细菌乘虚而入,引发膀胱炎。若没有得到及时的治疗,病菌会沿尿路上行,可引起肾盂肾炎。
长期反复的慢性感染还会造成肾功能损害,甚至尿毒症。因此,要做到有尿即排,才能维护尿道健康。
5. 避免劳累
对于免疫力低下的糖尿病患者,劳累后很容易导致尿路感染的症状复发,必要时要卧床休息,避免劳累。
文中配图部分来源网络,如有侵权,请联系删除。